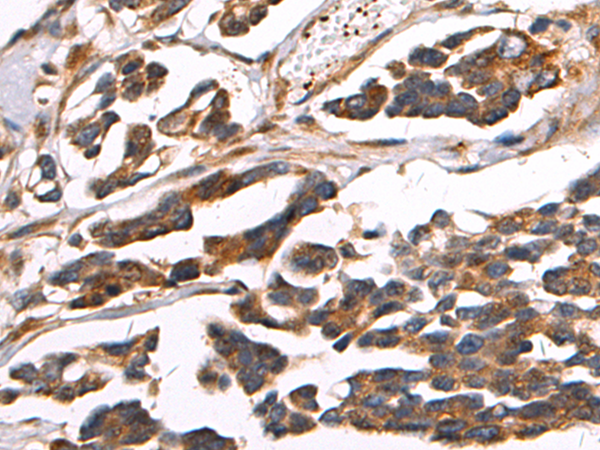

-
分类: 科研抗体货号: P13735别名: FLA8; HH0048; KLP-11应用: IHC反应种属: Human, Mouse
-
分类: 科研抗体货号: P13714别名: L7; humL7-1应用: IHC反应种属: Human, Mouse, Rat
-
分类: 科研抗体货号: P13733别名: SELM; SEPM应用: IHC反应种属: Human, Mouse
-
分类: 科研抗体货号: P13713别名: TOPI应用: WB,IHC反应种属: Human, Mouse, Rat
-
分类: 科研抗体货号: P13732别名: CNT1; HCNT1; URCTU应用: WB,IHC反应种属: Human
-
分类: 科研抗体货号: P13712别名: LAMPA; CD107a; LGP120应用: IHC反应种属: Human
-
分类: 科研抗体货号: P13711别名: MSE1; gluRS; COXPD12应用: IHC反应种属: Human, Mouse
-
分类: 科研抗体货号: P13729别名: Tilp; Psti-1; Spink1应用: WB,IHC反应种属: Human, Rat
-
分类: 科研抗体货号: P13710别名: DBC1; DBC-1; NET35; p30DBC; p30 DBC; KIAA1967应用: IHC反应种属: Human, Mouse
-
分类: 科研抗体货号: P13728别名: CT80; HILI; mili; PIWIL1L应用: IHC反应种属: Human, Mouse

鄂公网安备42018502007531号
鄂公网安备42018502007531号

